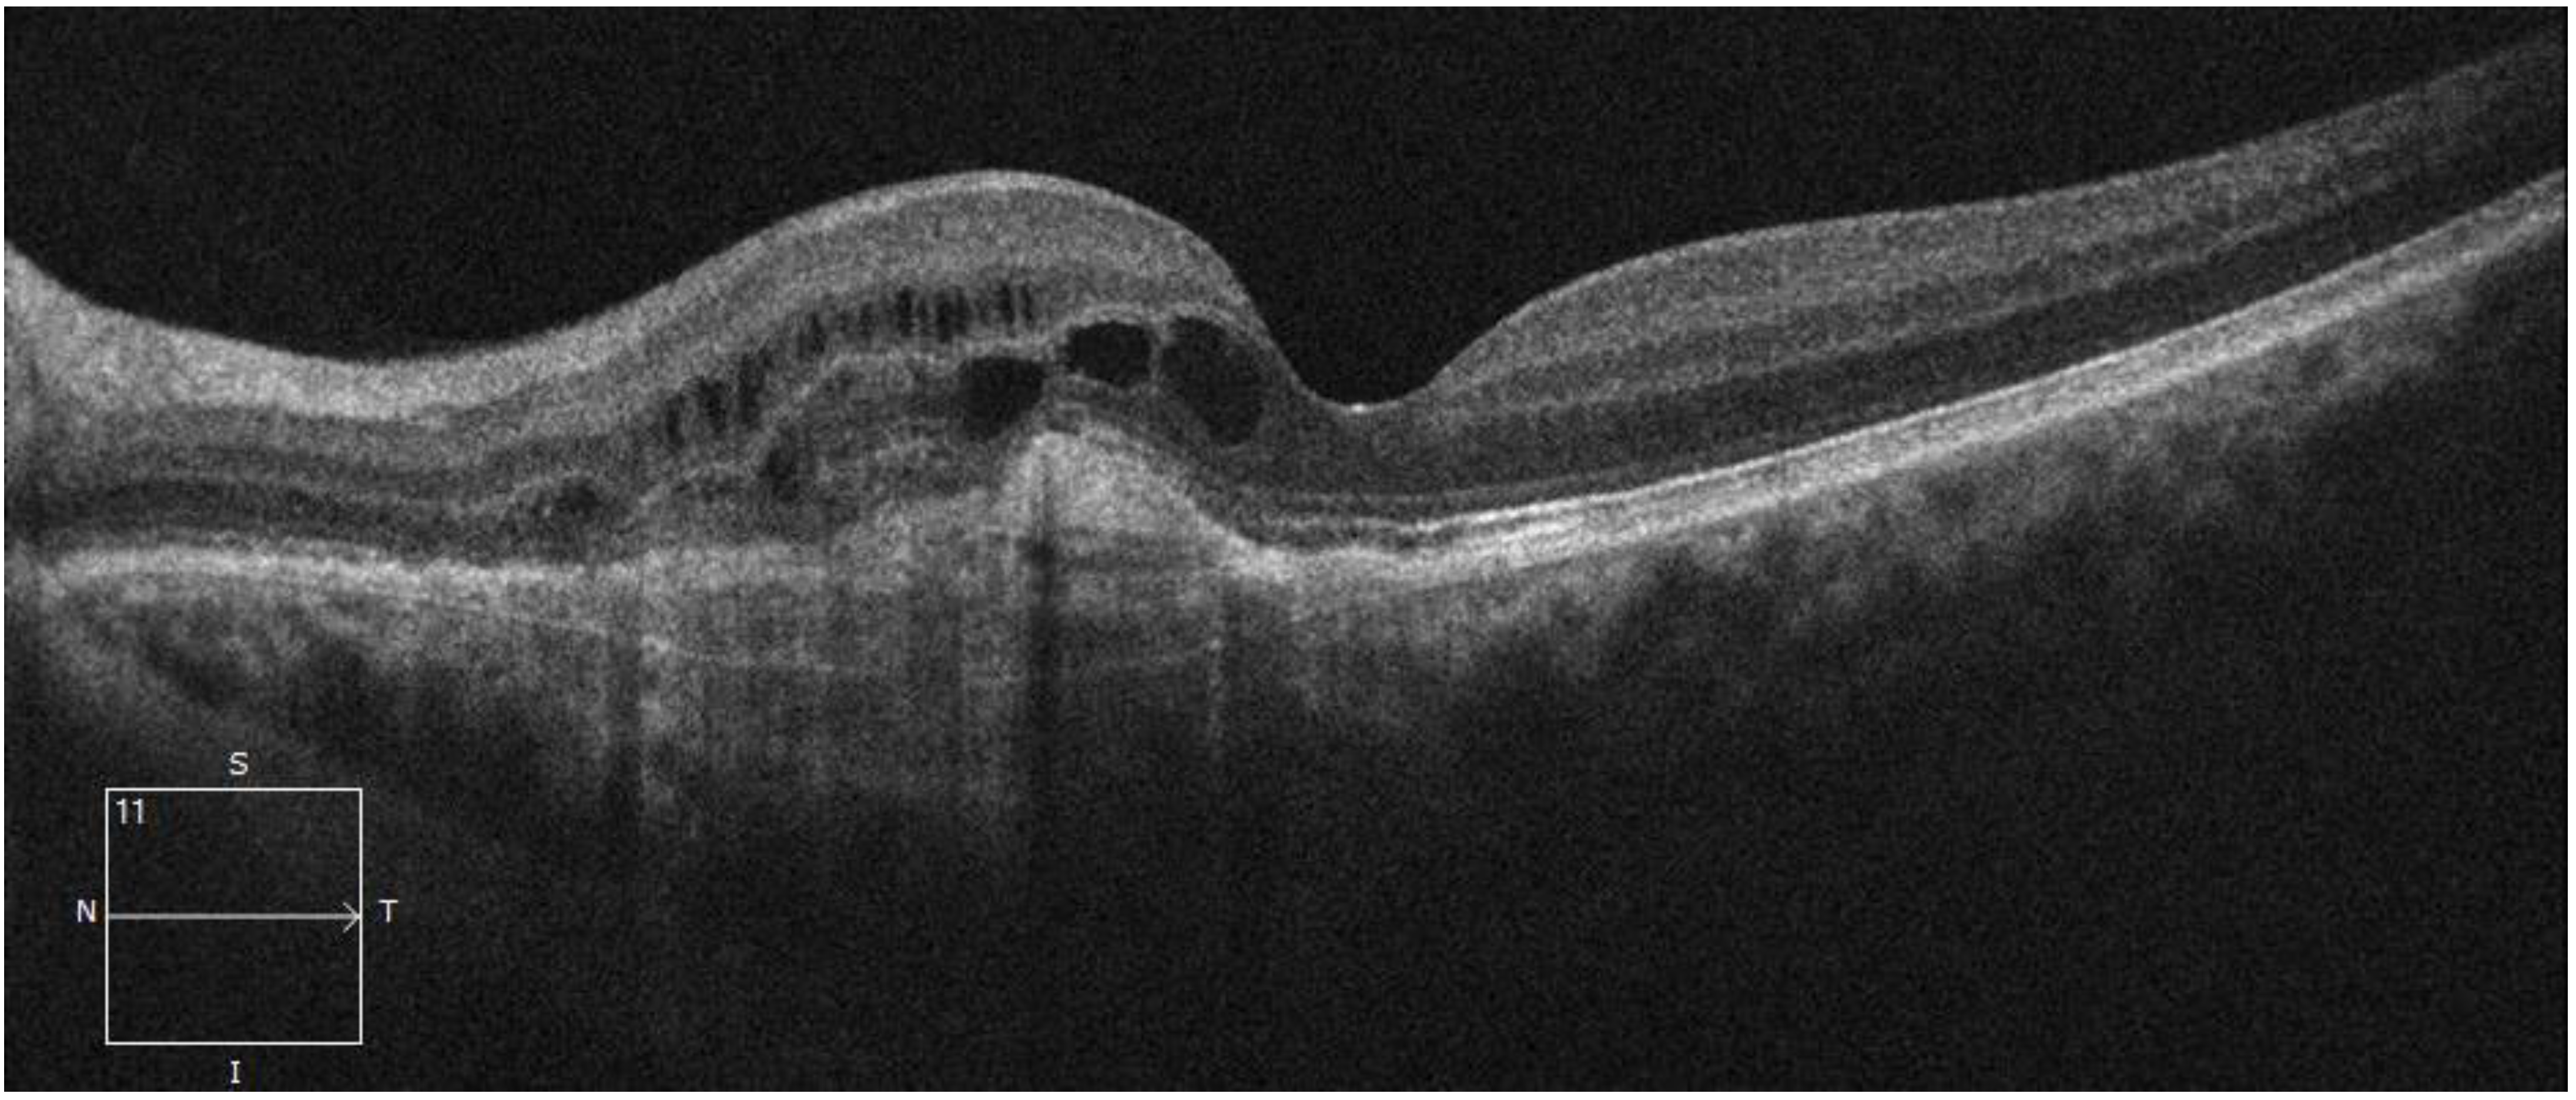
Life 15 00031 g005

Postpartum Exudation of Idiopathic Quiescent Macular Neovascularization: A Narrative Review with a Related Case Report
Abstract
1. Introduction
2. Idiopathic MNV
2.1. Definition
2.2. Diagnosis and Treatment
2.3. Idiopathic MNV in Young Patients
2.4. Idiopathic MNV in Pregnant Young Women
3. Quiescent MNV
3.1. Definition
3.2. Diagnosis of Quiescent MNV
4. Case Description
5. Discussion
6. Conclusions
Author Contributions
Funding
Institutional Review Board Statement
Informed Consent Statement
Data Availability Statement
Conflicts of Interest
References
- Sheth, J.U.; Stewart, M.W.; Narayanan, R.; Anantharaman, G.; Chandran, K.; Lai, T.Y.Y.; Chakravarthy, U.; Das, T. Macular neovascularization. Surv. Ophthalmol. 2024. Online ahead of print. [Google Scholar] [CrossRef] [PubMed]
- Carnevali, A.; Mastropasqua, R.; Gatti, V.; Vaccaro, S.; Mancini, A.; D’Aloisio, R.; Lupidi, M.; Cerquaglia, A.; Sacconi, R.; Borrelli, E.; et al. Optical Coherence Tomography Angiography in Intermediate and Late Age-Related Macular Degeneration: Review of Current Technical Aspects and Applications. Appl. Sci. 2020, 10, 8865. [Google Scholar] [CrossRef]
- Viana, A.R.; Lemos, J.; Oliveira, M.A.; Teixeira, C. Intravitreal aflibercept for idiopathic choroidal neovascularisation in paediatric age. BMJ Case Rep. 2023, 16, e252270. [Google Scholar] [CrossRef] [PubMed]
- Zhu, W.; Hao, Y.; Yuan, Z.; Huang, C.; Liu, J.; Ma, Y. Long-Term Outcomes of High-Dose Conbercept Treatment for Myopic Choroidal Neovascularization and Idiopathic Choroidal Neovascularization. Ophthalmic Res. 2023, 66, 636–644. [Google Scholar] [CrossRef]
- Shao, Z.; Li, S.; Yu, X.; Wang, J.; Liu, H.; Zhang, Y.; Huang, C.; Zhou, F.; Li, J. Intravitreal Conbercept for Idiopathic Choroidal Neovascularization in Nursing Women. Breastfeed. Med. 2021, 16, 915–918. [Google Scholar] [CrossRef] [PubMed]
- Wu, Q.; Chen, X.; Feng, K.; Liu, Y.; Zhang, C.; Zhao, L. Evaluation of efficacy and recurrence for anti-vascular endothelial growth factor therapy in idiopathic choroidal neovascularization. BMC Ophthalmol. 2020, 20, 115. [Google Scholar] [CrossRef] [PubMed]
- Querques, G.; Srour, M.; Massamba, N.; Georges, A.; Ben Moussa, N.; Rafaeli, O.; Souied, E.H. Functional characterization and multimodal imaging of treatment-naive “quiescent” choroidal neovascularization. Invest. Ophthalmol. Vis. Sci. 2013, 54, 6886–6892. [Google Scholar] [CrossRef] [PubMed]
- Giani, A.; Luiselli, C.; Esmaili, D.D.; Salvetti, P.; Cigada, M.; Miller, J.W.; Staurenghi, G. Spectral-domain optical coherence tomography as an indicator of fluorescein angiography leakage from choroidal neovascularization. Invest. Ophthalmol. Vis. Sci. 2011, 52, 5579–5586. [Google Scholar] [CrossRef]
- Miller, D.G.; Singerman, L.J. Vision loss in younger patients: A review of choroidal neovascularization. Optom. Vis. Sci. 2006, 83, 316–325. [Google Scholar] [CrossRef] [PubMed]
- Yang, F.; Dou, H.L.; Ma, Z.; Li, Y.L.; Lu, X.R.; Wang, X.; He, P.-P. Serum inflammatory factors in patients with idiopathic choroidal neovascularization. Ocul. Immunol. Inflamm. 2010, 18, 390–394. [Google Scholar] [CrossRef]
- Lee, J.E.; Shin, M.K.; Chung, I.Y.; Lee, J.E.; Kim, H.W.; Lee, S.J.; Park, S.W.; Byon, I.S. Topographical relationship between the choroidal watershed zone and submacular idiopathic choroidal neovascularisation. Br. J. Ophthalmol. 2016, 100, 652–659. [Google Scholar] [CrossRef] [PubMed][Green Version]
- Zhai, G.; Su, Y.; Wang, S.; Lu, H.; Liu, N. Efficacy and safety of intravitreal injections of conbercept for the treatment of idiopathic choroidal neovascularization. BMC Ophthalmol. 2024, 24, 75. [Google Scholar] [CrossRef]
- Mitchell, P.; Holz, F.G.; Hykin, P.; Midena, E.; Souied, E.; Allmeier, H.; Lambrou, G.; Schmelter, T.; Wolf, S.; ARIES Study Investigators. Efficacy and safety of intravitreal aflibercept using a treat-and-extend regimen for neovascular age-related macular degeneration: The ARIES Study: A Randomized Clinical Trial. Retina 2021, 41, 1911–1920. [Google Scholar] [CrossRef]
- Saurabh, K.; Roy, R.; Panigrahi, P.K.; Lobo, A.; Majumdar, A.K. Pro re nata intravitreal bevacizumab for the treatment of idiopathic choroidal neovascular membrane. Semin. Ophthalmol. 2016, 31, 463–466. [Google Scholar] [CrossRef]
- Mohammadpour, M.; Lashay, A.; Saeedi Anari, G.; Abdi, F.; Kermanshahani, A. Idiopathic Choroidal Neovascularization in a 23-Year-Old Girl. Arch. Iran. Med. 2015, 18, 453–455. [Google Scholar] [PubMed]
- Khan, M.A.; Bhalla, S.; Gurunadh, V.S.; Mohindra, V.K.; Reddy, S. A case of idiopathic choroidal neovascular membrane in a young patient. Med. J. Armed Forces India 2015, 71 (Suppl. S2), S493–S495. [Google Scholar] [CrossRef]
- Waheeb, S.A.; Showail, M.J. Idiopathic choroidal neovascular membrane in a young female. Oman J. Ophthalmol. 2009, 2, 133–136. [Google Scholar] [PubMed]
- Anastasilakis, K.; Symeonidis, C.; Kaprinis, K.; Mataftsi, A.; Tzamalis, A.; Dimitrakos, S.A. Peripapillary Neovascular Membrane in a Young Pregnant Woman and Prompt Response to Ranibizumab Injections following Uneventful Delivery. Case Rep. Ophthalmol. 2011, 2, 129–133. [Google Scholar] [CrossRef] [PubMed]
- Monis, M.D.; Ali, S.M.; Bhutto, I.A.; Mahar, P.S. Idiopathic Choroidal Neovascularization in Pregnancy: A Case Report. Cureus 2023, 15, e34611. [Google Scholar] [CrossRef]
- Fossum, P.; Couret, C.; Briend, B.; Weber, M.; Lagarce, L. Safety of intravitreal injection of ranibizumab in early pregnancy: A series of three cases. Eye 2018, 32, 830–832. [Google Scholar] [CrossRef]
- De Silva, S.R.; Bibi, F.; Sim, K.; Bindra, M.S. Idiopathic choroidal neovascularisation in pregnancy: Treatment options and a successful outcome. BMJ Case Rep. 2016, 2016, bcr2016215787. [Google Scholar] [CrossRef] [PubMed]
- Jouve, L.; Akesbi, J.; Nordmann, J.P. Safety and efficacy of ranibizumab for pregnant women in idiopathic choroidal neovascularization. Acta Ophthalmol. 2015, 93, e597–e598. [Google Scholar] [CrossRef]
- Sarhianaki, A.; Katsimpris, A.; Petropoulos, I.K.; Livieratou, A.; Theoulakis, P.E.; Katsimpris, J.M. Intravitreal administration of ranibizumab for idiopathic choroidal neovascularization in a pregnant woman. Klin. Monatsblatter Augenheilkd. 2012, 229, 451–453. [Google Scholar] [CrossRef] [PubMed]
- Querques, G.; Sacconi, R.; Capuano, V.; Carnevali, A.; Colantuono, D.; Battista, M.; Borrelli, E.; Miere, A.; Parravano, M.; Costanzo, E.; et al. Treatment-naïve quiescent macular neovascularization secondary to AMD: The 2019 Young Investigator Lecture of Macula Society. Eur. J. Ophthalmol. 2021, 31, 3164–3176. [Google Scholar] [CrossRef]
- Sacconi, R.; Fragiotta, S.; Sarraf, D.; Sadda, S.R.; Freund, K.B.; Parravano, M.; Corradetti, G.; Cabral, D.; Capuano, V.; Miere, A.; et al. Towards a better understanding of non-exudative choroidal and macular neovascularization. Prog. Retin. Eye Res. 2023, 92, 101113. [Google Scholar] [CrossRef] [PubMed]
- Spaide, R.F.; Jaffe, G.J.; Sarraf, D.; Freund, K.B.; Sadda, S.R.; Staurenghi, G.; Waheed, N.K.; Chakravarthy, U.; Rosenfeld, P.J.; Holz, F.G.; et al. Consensus Nomenclature for Reporting Neovascular Age-Related Macular Degeneration Data: Consensus on Neovascular Age-Related Macular Degeneration Nomenclature Study Group. Ophthalmology 2020, 127, 616–636. [Google Scholar] [CrossRef]
- Capuano, V.; Miere, A.; Querques, L.; Sacconi, R.; Carnevali, A.; Amoroso, F.; Bandello, F.; Souied, E.H.; Querques, G. Treatment-Naïve Quiescent Choroidal Neovascularization in Geographic Atrophy Secondary to Nonexudative Age-Related Macular Degeneration. Am. J. Ophthalmol. 2017, 182, 45–55. [Google Scholar] [CrossRef] [PubMed]
- Carnevali, A.; Capuano, V.; Sacconi, R.; Querques, L.; Marchese, A.; Rabiolo, A.; Souied, E.; Scorcia, V.; Bandello, F.; Querques, G. OCT Angiography of Treatment-Naïve Quiescent Choroidal Neovascularization in Pachychoroid Neovasculopathy. Ophthalmol. Retin. 2017, 1, 328–332. [Google Scholar] [CrossRef]
- Mentes, J.; Karaca, I.; Sermet, F. Multimodal imaging characteristics of quiescent type 1 neovascularization in an eye with angioid streaks. Am. J. Ophthalmol. Case Rep. 2018, 10, 132–136. [Google Scholar] [CrossRef]
- Carnevali, A.; Sacconi, R.; Querques, L.; Corbelli, E.; Rabiolo, A.; Chiara, G.; Scorcia, V.; Bandello, F.; Querques, G. Abnormal quiescent neovascularization in a patient with large colloid drusen visualized by optical coherence tomography angiography. Retin. Cases Brief Rep. 2018, 12 (Suppl. S1), S41–S45. [Google Scholar] [CrossRef]
- Sato, T.; Kishi, S.; Watanabe, G.; Matsumoto, H.; Mukai, R. Tomographic features of branching vascular networks in polypoidal choroidal vasculopathy. Retina 2007, 27, 589–594. [Google Scholar] [CrossRef]
- Shi, Y.; Motulsky, E.H.; Goldhardt, R.; Zohar, Y.; Thulliez, M.; Feuer, W.; Gregori, G.; Rosenfeld, P.J. Predictive Value of the OCT Double-Layer Sign for Identifying Subclinical Neovascularization in Age-Related Macular Degeneration. Ophthalmol. Retin. 2019, 3, 211–219. [Google Scholar] [CrossRef] [PubMed]
- Narita, C.; Wu, Z.; Rosenfeld, P.J.; Yang, J.; Lyu, C.; Caruso, E.; McGuinness, M.; Guymer, R.H. Structural OCT Signs Suggestive of Subclinical Nonexudative Macular Neovascularization in Eyes with Large Drusen. Ophthalmology 2020, 127, 637–647. [Google Scholar] [CrossRef] [PubMed]
- Carnevali, A.; Cicinelli, M.V.; Capuano, V.; Corvi, F.; Mazzaferro, A.; Querques, L.; Scorcia, V.; Souied, E.H.; Bandello, F.; Querques, G. Optical Coherence Tomography Angiography: A Useful Tool for Diagnosis of Treatment-Naïve Quiescent Choroidal Neovascularization. Am. J. Ophthalmol. 2016, 169, 189–198. [Google Scholar] [CrossRef] [PubMed]
- Laiginhas, R.; Yang, J.; Rosenfeld, P.J.; Falcão, M. Nonexudative Macular Neovascularization—A Systematic Review of Prevalence, Natural History, and Recent Insights from OCT Angiography. Ophthalmol. Retin. 2020, 4, 651–661. [Google Scholar] [CrossRef]
- Hermesch, A.C.; Kernberg, A.S.; Layoun, V.R.; Caughey, A.B. Oxytocin: Physiology, pharmacology, and clinical application for labor management. Am. J. Obstet. Gynecol. 2024, 230, S729–S739. [Google Scholar] [CrossRef] [PubMed]
- Metrangolo, C.; Donati, S.; Mazzola, M.; Fontanel, L.; Messina, W.; D’alterio, G.; Rubino, M.; Radice, P.; Premi, E.; Azzolini, C. OCT Biomarkers in Neovascular Age-Related Macular Degeneration: A Narrative Review. J. Ophthalmol. 2021, 2021, 9994098. [Google Scholar] [CrossRef]
- Fouad, Y.A.; Santina, A.; Bousquet, E.; Sadda, S.R.; Sarraf, D. Pathways of Fluid Leakage in Age-Related Macular Degeneration. Retina 2023, 43, 873–881. [Google Scholar] [CrossRef] [PubMed]
- Santina, A.; Romero-Morales, V.; Abraham, N.; Somisetty, S.; Fogel-Levin, M.; Bousquet, E.; Nudleman, E.; Sadda, S.; Sarraf, D. Non-neovascular fluid in age-related macular degeneration: Observe-and-extend regimen in a case-series study. Can. J. Ophthalmol. 2023, 58, 592–600. [Google Scholar] [CrossRef]
- Forte, R.; Coscas, F.; Serra, R.; Cabral, D.; Colantuono, D.; Souied, E.H. Long-term follow-up of quiescent choroidal neovascularisation associated with age-related macular degeneration or pachychoroid disease. Br. J. Ophthalmol. 2020, 104, 1057–1063. [Google Scholar] [CrossRef]
- Carnevali, A.; Sacconi, R.; Querques, L.; Marchese, A.; Capuano, V.; Rabiolo, A.; Corbelli, E.; Panozzo, G.; Miere, A.; Souied, E.; et al. Natural History of Treatment-Naïve Quiescent Choroidal Neovascularization in Age-Related Macular Degeneration Using OCT Angiography. Ophthalmol. Retin. 2018, 2, 922–930. [Google Scholar] [CrossRef] [PubMed]
- Nuzzi, R.; Caselgrandi, P. Sex Hormones and Their Effects on Ocular Disorders and Pathophysiology: Current Aspects and Our Experience. Int. J. Mol. Sci. 2022, 23, 3269. [Google Scholar] [CrossRef] [PubMed]
- Nuzzi, R.; Scalabrin, S.; Becco, A.; Panzica, G. Gonadal Hormones and Retinal Disorders: A Review. Front. Endocrinol. 2018, 9, 66. [Google Scholar] [CrossRef] [PubMed]
- Cascio, C.; Deidda, I.; Russo, D.; Guarneri, P. The estrogenic retina: The potential contribution to healthy aging and age-related neurodegenerative diseases of the retina. Steroids 2015, 103, 31–41. [Google Scholar] [CrossRef] [PubMed]
- Behar-Cohen, F.; Zhao, M. Mineralocorticoid pathway in retinal health and diseases. Br. J. Pharmacol. 2022, 179, 3190–3204. [Google Scholar] [CrossRef] [PubMed]
- Ahmad, S.B.; Ali, A.; Bilal, M.; Rashid, S.M.; Wani, A.B.; Bhat, R.R.; Rehman, M.U. Melatonin and Health: Insights of Melatonin Action, Biological Functions, and Associated Disorders. Cell Mol. Neurobiol. 2023, 43, 2437–2458. [Google Scholar] [CrossRef] [PubMed]
- Ma, C.; Li, H.; Lu, S.; Li, X. The Role and Therapeutic Potential of Melatonin in Degenerative Fundus Diseases: Diabetes Retinopathy and Age-Related Macular Degeneration. Drug Des. Devel Ther. 2024, 18, 2329–2346. [Google Scholar] [CrossRef] [PubMed]
- Valero-Ochando, J.; Cantó, A.; López-Pedrajas, R.; Almansa, I.; Miranda, M. Role of Gonadal Steroid Hormones in the Eye: Therapeutic Implications. Biomolecules 2024, 14, 1262. [Google Scholar] [CrossRef] [PubMed]
- Li, N.; Zhu, Z.; Yi, G.; Li, S.; Han, X. Valsalva Retinopathy in Twin-Pregnancy: A Case Report and Literature Review. Am. J. Case Rep. 2018, 19, 5–9. [Google Scholar] [CrossRef]
- Nguyen, B.N.; Britten-Jones, A.C.; Bui, B.V.; Walker, L.E.; Titter, P. Physiological and pathological changes to the eye and vision during and after pregnancy. Clin. Exp. Optom. 2024. Online ahead of print. [Google Scholar] [CrossRef] [PubMed]
- Halbach, P.; Pillers, D.A.; York, N.; Asuma, M.P.; Chiu, M.A.; Luo, W.; Tokarz, S.; Bird, I.M.; Pattnaik, B.R. Oxytocin expression and function in the posterior retina: A novel signaling pathway. Invest. Ophthalmol. Vis. Sci. 2015, 56, 751–760. [Google Scholar] [CrossRef] [PubMed]
- York, N.; Halbach, P.; Chiu, M.A.; Bird, I.M.; Pillers, D.M.; Pattnaik, B.R. Oxytocin (OXT)-stimulated inhibition of Kir7.1 activity is through PIP2-dependent Ca2+ response of the oxytocin receptor in the retinal pigment epithelium in vitro. Cell Signal. 2017, 37, 93–102. [Google Scholar] [CrossRef] [PubMed]
- Hu, S.; Wang, Y.; Han, X.; Dai, M.; Zhang, Y.; Ma, Y.; Weng, S.; Xiao, L. Activation of oxytocin receptors in mouse GABAergic amacrine cells modulates retinal dopaminergic signaling. BMC Biol. 2022, 20, 205. [Google Scholar] [CrossRef] [PubMed]
- Drugs and Lactation Database (LactMed®). In 2006 Oxytocin; National Institute of Child Health and Human Development: Bethesda, MD, USA, 2023.

| Idiopathic MNV | Quiescent MNV | |
|---|---|---|
| Onset | Under 50 years | Over 50 years |
| Symptoms | Decreased visual acuity Metamorphopsia Micropsia Photopsia Decreased color vision | Typically asymptomatic |
| OCT/OCTA | Presence of different signs of exudation, depending on type of MNV | Presence of two hyperreflective layers (RPE and the Bruch membrane) with a major axis on the horizontal plane, and with the presence of reflective material inside, in the absence of subretinal fluid (double-layer sign). Presence of a well-defined neovascular network, in the absence of exudation |
| FA | Presence of dye pooling, depending on type of MNV | Late speckled hyperfluorescent lesions lacking well-demarcated borders, without pooling of dye in the subretinal space or late-phase leakage of an unknown source |
| ICGA | Presence of dye pooling, depending on type of MNV | In the mid-late phase, the lesion appears as a distinct plaque, similarly to typical exudative type 1 MNV |
| Treatment | Intravitreal anti-VEGF drugs | No therapy |
Disclaimer/Publisher’s Note: The statements, opinions and data contained in all publications are solely those of the individual author(s) and contributor(s) and not of MDPI and/or the editor(s). MDPI and/or the editor(s) disclaim responsibility for any injury to people or property resulting from any ideas, methods, instructions or products referred to in the content. |
© 2024 by the authors. Licensee MDPI, Basel, Switzerland. This article is an open access article distributed under the terms and conditions of the Creative Commons Attribution (CC BY) license (https://creativecommons.org/licenses/by/4.0/).
Share and Cite
Vitiello, L.; De Bernardo, M.; De Pascale, I.; Salerno, G.; Pellegrino, A.; Rosa, N. Postpartum Exudation of Idiopathic Quiescent Macular Neovascularization: A Narrative Review with a Related Case Report. Life 2025, 15, 31. https://doi.org/10.3390/life15010031
Vitiello L, De Bernardo M, De Pascale I, Salerno G, Pellegrino A, Rosa N. Postpartum Exudation of Idiopathic Quiescent Macular Neovascularization: A Narrative Review with a Related Case Report. Life. 2025; 15(1):31. https://doi.org/10.3390/life15010031
Chicago/Turabian StyleVitiello, Livio, Maddalena De Bernardo, Ilaria De Pascale, Giulio Salerno, Alfonso Pellegrino, and Nicola Rosa. 2025. "Postpartum Exudation of Idiopathic Quiescent Macular Neovascularization: A Narrative Review with a Related Case Report" Life 15, no. 1: 31. https://doi.org/10.3390/life15010031
APA StyleVitiello, L., De Bernardo, M., De Pascale, I., Salerno, G., Pellegrino, A., & Rosa, N. (2025). Postpartum Exudation of Idiopathic Quiescent Macular Neovascularization: A Narrative Review with a Related Case Report. Life, 15(1), 31. https://doi.org/10.3390/life15010031









